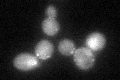
YGL181W
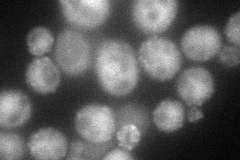
YGL181W
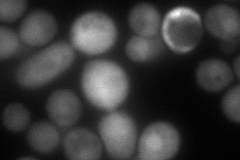
YGL181W
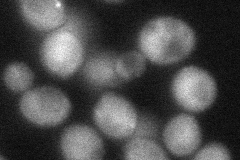
YGL181W
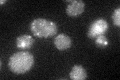
YGL181W

View description
Arf3p GTPase Activating Protein (GAP) that localizes to endocytic patches; gts1 mutations affect budding, cell size, heat tolerance, sporulation, life span, ultradian rhythms; localizes to nucleus and induces flocculation when overexpressed
Localization:
Intensity:
Fold change:
Significance:
-
C’ GFP library in SD
punctate36.93 -
N' NOP1pr-GFP in SD
cytosol,punctate,bud neck,nucleus86.75 -
N' TEF2pr-mCherry in SD
cytosol,nucleus,bud141.542 -
N' NATIVEpr-GFP in SD

punctate,bud neck41.7265 -
N' TEF2pr-VC and Cyto-VN in SD
cytosol48.7048 -
C’ GFP library in SD+DTT

punctate40.561.09No -
C’ GFP library in SD+H2O2

punctate44.461.2No -
C’ GFP library in Starvation Media
punctate63.411.71Yes -
C’ GFP library on the background of Pup2-DaMP

punctate -
C’ GFP library on the background of CCT mutant

punctate39.59391.07195No
